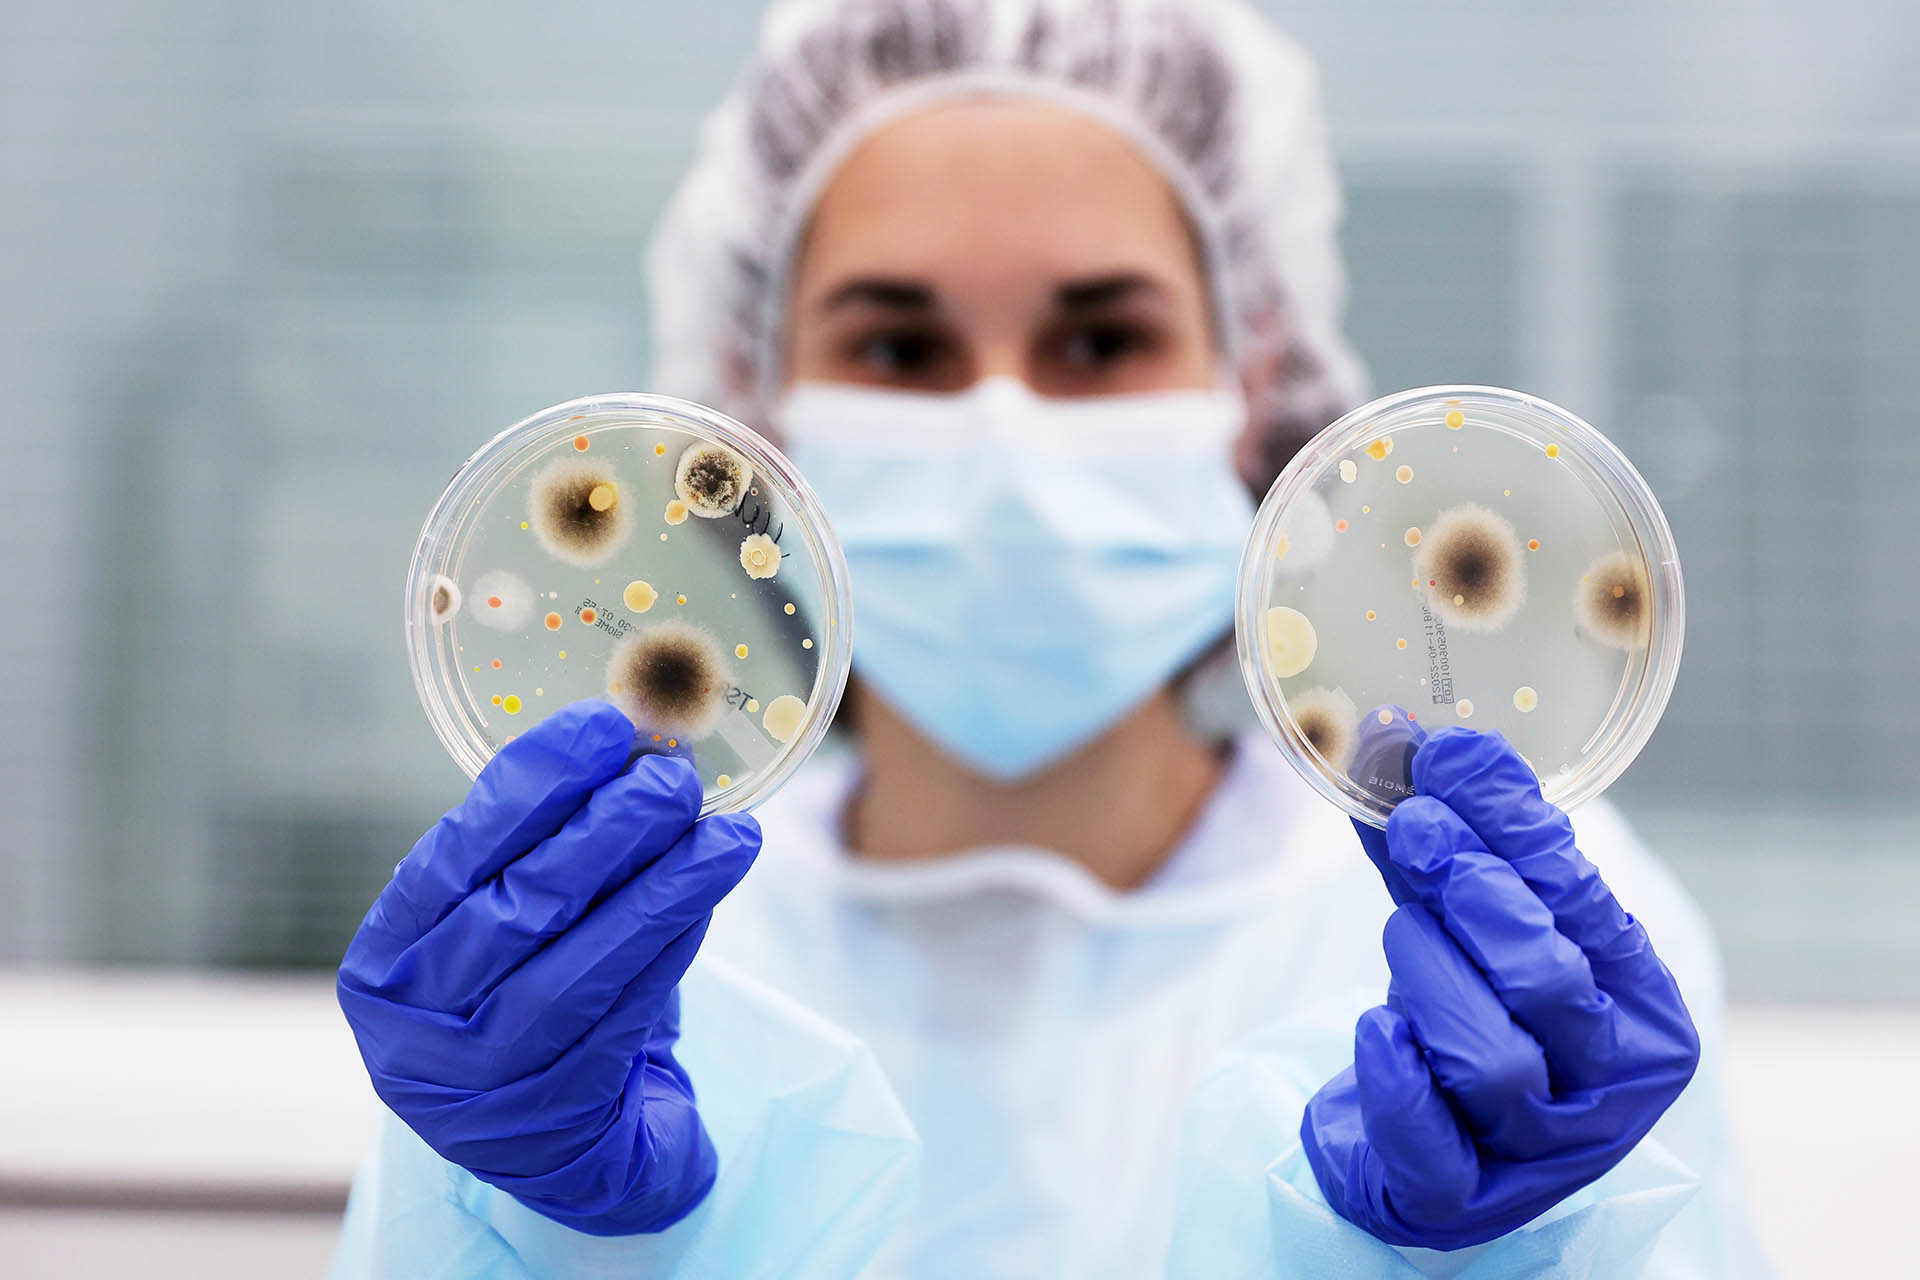

Подмосковному городу Долгопрудному, одному из крупнейших центров развития науки и современных технологий, присвоен статус наукограда Российской Федерации. Соответствующее распоряжение подписал председатель Правительства Михаил Мишустин.
Присвоение статуса позволит городу получать федеральное финансирование на обеспечение работы и модернизацию научно-производственных комплексов, а также на реализацию стратегии социально-экономического развития. Средства будут выделяться в рамках федерального проекта «Поддержка наукоградов», который входит в государственную программу «Научно-технологическое развитие Российской Федерации». Согласно законодательству, статус наукограда присваивается на 15 лет, поэтому решение будет действовать до 2041 года.
В Долгопрудном расположен Московский физико-технический институт (МФТИ), который является ядром научного потенциала города. В мае 2025 года по инициативе МФТИ правительство утвердило решение о создании инновационного научно-технологического центра «Долина Физтеха». Основными направлениями его работы станут разработки в сфере микроэлектроники, развитие квантовых, биомедицинских, телекоммуникационных и аэрокосмических технологий, а также исследования в области искусственного интеллекта, робототехники и беспилотного транспорта.